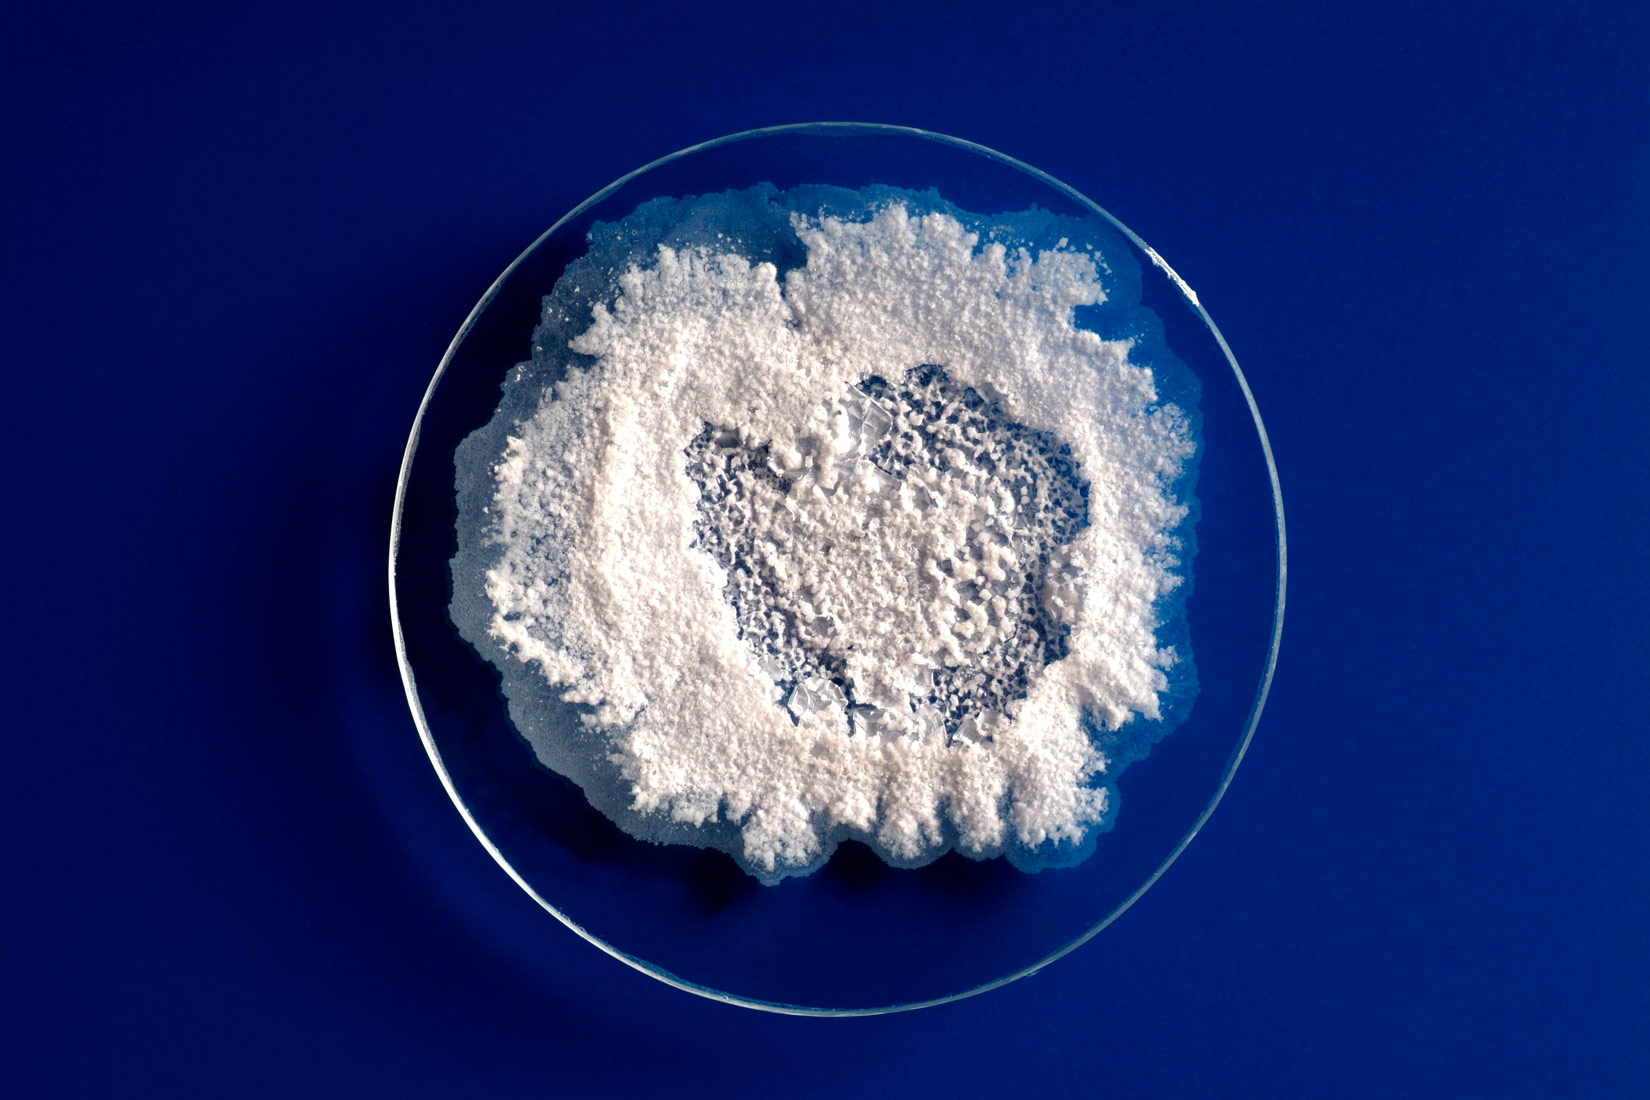
Na slici je prikazano satno stakalce okruglog oblika na kojem se vidi bijela mrlja soli. Stakalce je na tamnoplavoj podlozi.

Postupci odvajanja sastojaka homogenih smjesa
- navesti neke homogene smjese iz svakodnevnog života
- primijeniti postupke odvajanja sastojaka iz homogene smjese (hlapljenje, isparavanje, kristalizacija, destilacija)
- predložiti postupak izdvajanja sastojaka iz smjese na osnovi poznavanja fizikalnih i kemijskih svojstava sastojaka smjese.
Uvod
Je li čisti zrak
Zamisli neku homogenu smjesu.
Na primjer slanu vodu.
Želimo ispitati svojstva pojedinog sastojka u homogenoj smjesi.
Prvo moramo izdvojiti sastojke iz te homogene smjese.
Kako ćemo odijeliti sastojke iz homogene smjese ovisi o fizikalnim svojstvima pojedinih sastojaka.
Postupci za odvajanje tvari iz homogenih smjesa su:
1. hlapljenje
2. isparavanje
3. destilacija
4. kristalizacija.
Hlapljenje i isparavanje slane vode
Isparavanjem i hlapljenjem vode iz otopine kuhinjske soli
na stakalcu ostaje bijela mrlja soli.
Želimo li ispitati svojstva pojedinih sastojaka u homogenoj smjesi, moramo ih najprije izdvojiti. Odabir metode ili postupka kojim želimo odijeliti sastojke iz homogene smjese ovisi o fizikalnim svojstvima pojedinog sastojka smjese.
Postupci za odvajanje tvari iz homogenih smjesa su: hlapljenje i isparavanje, destilacija i kristalizacija.
Hlapljenje i isparavanje slane vode
Isparavanjem i hlapljenjem vode iz otopine kuhinjske soli na stakalcu ostaje bijela mrlja soli.
Hlapljenje je sporiji proces jer se zbiva pri temperaturi nižoj od vrelišta.
Za isparavanje treba otopinu zagrijati do vrelišta.
Na oba smo načina iz smjese odvojili i sačuvali sol,
ali smo uklonili vodu.
Hlapljenje je sporiji proces jer se zbiva pri temperaturi nižoj od vrelišta, a za isparavanje treba otopinu zagrijati do vrelišta. Na oba smo načina iz smjese odvojili i sačuvali sol, ali smo uklonili vodu.
Dobivanje soli u solanama
Kristalizacija
Kristalizacija je izlučivanje kristala iz otopine.
Veličina i oblik kristala ovise o brzini kristalizacije.
Kristalizacija i poznavanje njezinih uvjeta
važni su za proizvodnju različitih kristala.
Kristali se koriste u suvremenim tehnologijama
npr. u laserima ili u vodičima u računalu.
Kristalizacija je izlučivanje kristala iz otopine. Veličina i oblik kristala ovise o brzini kristalizacije.
Kristalizacija i poznavanje njezinih uvjeta važni su za proizvodnju različitih kristala koji se koriste u suvremenim tehnologijama npr. u laserima ili u vodičima u računalu.
Ako ste u mogućnosti posjetite neku od izložbi kristala
što se povremeno održavaju u našim većim gradovima.
Uz prethodnu suglasnost organizatora,
fotografirajte neke od izloženih primjeraka kristala.
Pronađite u literaturi ili na stručnim mrežnim stranicama
svojstva svakog od njih.
Načinite interaktivni multimedijalni plakat
u alatu Piktochart
i potom ga objavite na mrežnoj stranici škole.
Ako ste u mogućnosti posjetite neku od izložbi kristala što se povremeno održavaju u našim većim gradovima.
Uz prethodnu suglasnost organizatora, fotografirajte neke od izloženih primjeraka kristala te pronađite u literaturi ili na stručnim mrežnim stranicama svojstva svakog od njih.
Načinite interaktivni multimedijalni plakat u alatu Piktochart i potom ga objavite na mrežnoj stranici škole.
Šećer se dobiva iz šećerne trske i iz šećerne repe.
Gusti sirup, šećerovina dobiva se fizikalnim i kemijskim postupcima.
Šećer se iz smjese izdvaja postupkom kristalizacije.
Tako dobiveni šećer ostavlja se sušiti u sušari.
Nakon sušenja šećer se pakira i šalje na tržište.
Istražite kako se dobivaju kristali šećera koje konzumiramo u kućanstvu.
Šećer se dobiva iz šećerne trske i iz šećerne repe. Nizom fizikalnih i kemijskih postupaka u šećeranama se dobiva gusti sirup, šećerovina. Šećer se iz smjese izdvaja postupkom kristalizacije. Tako dobiveni šećer ostavlja se sušiti u sušari. Nakon sušenja šećer se pakira i šalje na tržište.
Destilacija
Ako želimo odvojiti i sačuvati sve sastojke tekuće homogene smjese,
koristit ćemo se metodom destilacije.
Aparutara za destilaciju ima tri dijela:
- dio u kojem se nalazi početna smjesa
- hladilo – tu se vodena para kondenzira
- predložak – tu se para skuplja
Destilacija otopine modre galice
Tijekom zagrijavanja otopine modre galice voda prelazi u paru.
Hladi se prolazeći kroz središnju cijev.
Središnja cijev je hladilo .
U hladilu se voda ponovno kondenzira u tekućinu.
U tikvici za destilaciju zaostala je modra galica.
U Erlenmeyerovu tikvicu kaplje čista voda.
Ta čista voda se naziva destilat.
Destilacija je postupak prevođenja tekućine u paru
i kondenzacija pare u tekućinu.
Destilacija
Želimo li odvojiti i sačuvati sve sastojke neke tekuće homogene smjese, koristit ćemo se metodom destilacije.
Svaka aparatura za destilaciju ima tri dijela. Dio u kojem se nalazi početna smjesa, zatim dio u kojem nastala vodena para kondenzira – hladilo i dio u kojem se ukapljena para skuplja – predložak.
Destilacija otopine modre galice
Tijekom zagrijavanja otopine modre galice voda prelazi u paru, a hlađenjem – prolazeći kroz središnju cijev u hladilu – ponovno kondenzira u tekućinu.
U tikvici za destilaciju modra je otopina, a u Erlenmeyerovu tikvicu – predložak – kaplje čista bezbojna voda – destilat.
Destilacija je postupak prevođenja tekućine u paru i kondenzacija pare u tekućinu.
Istražite koji su konačni produkti destilacije vodene otopine modre galice. Predložite postupke kojima se mogu dobiti veliki i lijepi kristali modre galice.
Kod razdvajanja homogenih smjesa više tekućina
primjenjuje se poseban oblik destilacije –
To je postupak kojim se izdvajaju pojedine sastavnice (frakcije)
na temelju različitih vrelišta.
Frakcijska destilacija primjenjuje se pri dobivanju
sastojaka ukapljenog zraka
ili u rafinerijama nafte.
Istražite kojim se postupkom dobivaju žestoka alkoholna pića.
Korištenjem digitalnog alata Chemix
nacrtajte aparaturu za taj postupak.
Pripremite kratko izvješće u obliku prezentacije.
Prezentacijski alati su vam opisani
na mrežnoj stranici CARNetov e-Laboratorij
Kod razdvajanja homogenih smjesa više tekućina primjenjuje se poseban oblik destilacije –
To je postupak kojim se izdvajaju pojedine sastavnice (frakcije) na temelju različitih vrelišta. Frakcijska destilacija primjenjuje se pri dobivanju sastojaka ukapljenog zraka ili u rafinerijama nafte.
Istražite:
a) koje se elementarne tvari dobiju frakcijskom destilacijom ukapljenog zraka
b) kojim se postupkom dobivaju žestoka alkoholna pića.
Korištenjem digitalnog alata Chemix, koji je namijenjen za jednostavno crtanje kemijskih aparatura, nacrtajte aparaturu za taj postupak.
Pripremite kratko izvješće u obliku prezentacije u jednom od prezentacijskih alata koji su vam opisani na mrežnoj stranici CARNETova e-Laboratorija.
Zašto se kod sastavljanja aparature treba pridržavati predviđenih uputa?
Pri slaganju aparature za destilaciju Liebigovo hladilo se pod kutom
postavlja između tikvice za destilaciju i predloška.
U Liebigovom hladilu nastala se vodena para kondenzira u vodu .
Zatim se voda hvata u predložak.
Hladilo se gumenim cijevima povezuje s dovodom i odvodom vode.
Voda u hladilo mora ulaziti na nižoj,
a izlaziti na višoj strani hladila.
Istražite što bi se dogodilo kada bi promijenili položaj cijevi na hladilu.
Objasnite zašto se kod sastavljanja aparature
treba pridržavati predviđenih uputa.
Zašto se kod sastavljanja aparature treba pridržavati predviđenih uputa?
Pri slaganju aparature za destilaciju Liebigovo hladilo se pod kutom postavlja između tikvice za destilaciju i predloška. U Liebigovom hladilu nastala se vodena para kondenzira u vodu i hvata u predložak. Hladilo se gumenim cijevima povezuje s dovodom i odvodom vode. Voda u hladilo mora ulaziti na nižoj, a izlaziti na gornjoj višoj strani hladila.
Istražite što bi se dogodilo kada bi promijenili položaj cijevi na hladilu. Objasnite zašto se kod sastavljanja aparature treba pridržavati predviđenih uputa.
Na kraju…
Klikom odaberite jedan ili više točnih odgovora.
Odaberite sve točne odgovore.
Iz sljedećeg niza čistih tvari izdvoji dva kemijska spoja (točna su dva odgovora):
Klikom odaberite jedan točan odgovor.
Odaberite točan odgovor.
U kojem su od sljedećih nizova navedene samo elementarne tvari?
Je li tvrdnja točna ili netočna? Odaberite klikom na gumb.
Je li ova tvrdnja točna?
Postupci odvajanja sastojaka iz smjese su fizikalne promjene.
Je li tvrdnja točna ili netočna? Odaberite klikom na gumb.
Je li ova tvrdnja točna?
Destilacija se može primijeniti za odvajanje sastojaka iz otopina.
Je li tvrdnja točna ili netočna? Odaberite klikom na gumb.
Je li ova tvrdnja točna?
Kisik iz zraka odvaja se elektrolizom.
Je li tvrdnja točna ili netočna? Odaberite klikom na gumb.
Je li ova tvrdnja točna?
U prirodi je više kemijskih spojeva nego smjesa.
Je li tvrdnja točna ili netočna? Odaberite klikom na gumb.
Je li ova tvrdnja točna?
Homogene smjese su složene čiste tvari.
Želite li pokušati ponovo?